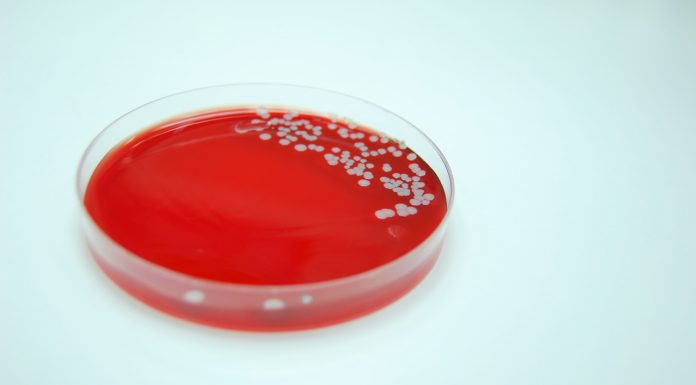
Nasal swab offers hope for reducing vancomycin use Bacterial Culture of Staphylococcus aureus

A study has found a pharmacy-driven protocol using nasal swabs to assess methicillin‑resistant Staphylococcus aureus (MRSA) in pneumonia cases holds promise for reducing unnecessary...
Cannabis is the most popular recreational drug used in the world. The use of cannabis or cannabinoids is referred to as medicinal cannabis.
Learning objectives...
Immortalised in Australian slang, the analgesic phenacetin (used in Bex powder) is wrapped up in the development of the modern pharmaceutical industry and has...
Alcohol is an important part of the Australian culture and way of life. Unfortunately, the nation’s love affair with alcohol has made it the...
Meningococcal disease is an acute bacterial infection that can affect the brain and spinal cord (meningitis), or the blood (septicaemia); whilst some patients can...
Immediate patient access to antibiotics through pharmacies has been recognised as a factor in addressing antibiotic misuse in the community, as antimicrobial resistance increases.
A...
From June, pharmacists across metro and regional Victoria will have access to free training sessions to help their patients quit smoking.
‘Pharmacists are highly respected...
A once-daily, single inhaler triple therapy for chronic obstructive pulmonary disease (COPD) is set to be listed on the PBS from 1 July.
The...
Drug dependence, including opioid dependence, involves a complex interplay of social, psychological and biological factors.
Learning objectives
After reading this article, pharmacists should be able...
Calculating doses is one of the many challenges faced when using medicines in children. To complicate matters, some medicines need to be given 'off-label' when...